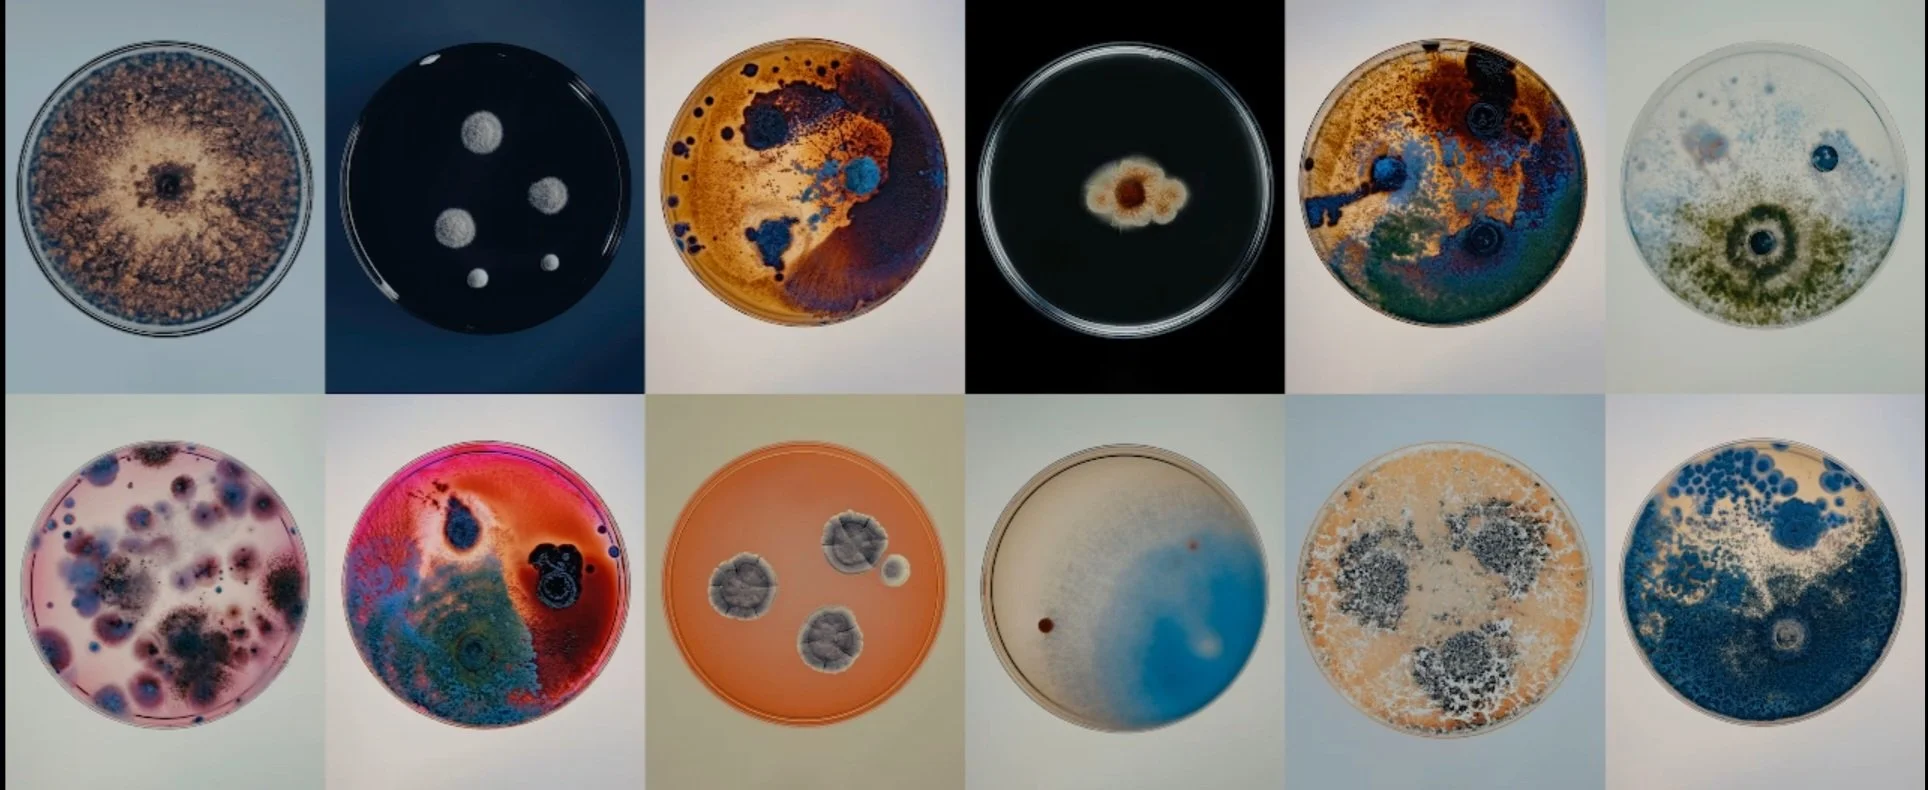

I create visual worlds — using photography, story logic, and poetic systems.
I work across concept development, image direction, photography, and experimental media — blending analog and digital tools, scientific references, and symbolic storytelling.
Available for creative collaborations, commissions, and project-based work.
I’m especially useful when the idea is strange, emotional, or still taking shape.
What I Offer
Visual Direction – mood, tone, composition, emotional logic
Concept Development – ideas, titles, story frameworks, campaign thinking
Photography – documentary, staged, or surreal (when needed)
Microscopic Imaging – real footage of invisible microbial worlds
AI Image & Motion – pre-viz, motion sketches, mood experiments
Everything I offer comes from the same root — no divide between art and utility.
Selected Projects
New Seas
Concept Development, Photography, Visual Strategy, Storytelling
Ongoing series exploring human impact on water systems using archaic analog photography methods together with sea as a co-author.
Handled every stage from concept to exhibition.
Awarded 1st place in the International Photography Awards.
Acquired by the Lithuanian National Museum of Art and 25+ private collectors.
Full series: https://www.pauliusmakauskas.com/work/newseas
12 Invisibles
Visual Direction, Microscopic Imaging, Concept Development
Commissioned visuals for a company using microorganisms to clean toxic soil.
Using microscopy tools developed in previous art research, we created surreal videos of microbial activity — making the unseen world cinematic, poetic, and alive.
Project co - author Petras Saulenas
Watch full video - https://www.pauliusmakauskas.com/work/12-invisibles
Everything is OK
Game Concept, Sound Design, Visual Direction, Narrative Systems
A ritual survival video game where sound bleeds, control slips, and meaning echoes in strange ways — where temptation spirals and obsessive choices shape a world that no longer bows and keeps evolving without you.
Includes AI motion sketches, analog sound design, and system-based storytelling.
Currently in development — open to creative and studio collaborations.
Watch sketches & read full game doc: https://www.pauliusmakauskas.com/work/everything-is-ok
Evacuation of the Gods
Concept Photography, Staged Narrative, Poetic Execution
A visual series imagining mythic beings quietly leaving a ruined world.
Mixes kitsch, theatricality, and slow emotional punch.
Can be presented as photo series, zine, or speculative campaign.
Explore project: https://www.pauliusmakauskas.com/work/evacuation-of-the-gods
Reincarnation Kit
Concept development, Visual Direction, Object Design, Storytelling, Emotional Systems, Symbolic Communication, Experimental Image - Making
The Reincarnation Kit is a ritual object — part science, part myth, part grief offering.
It invites you to grow your own microbes alongside soil from someone you’ve lost.
Together they live in a Petri dish — a shared dish, a reunion meal, a quiet gesture toward the unknown.
You won’t get answers. But you might feel something real.
This is not a performance. It’s a sincere attempt.
A small, living ritual for anyone who has loved and lost.